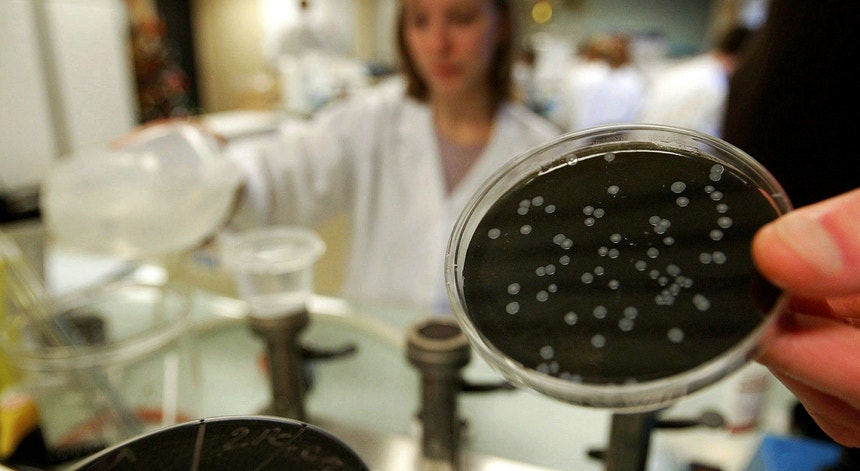

País
Surto de legionela provoca uma vítima mortal em Matosinhos
Uma pessoa morreu num surto de legionela no Centro Social de Leça do Balio, em Matosinhos. O Departamento de Saúde Pública confirma que há um outro caso confirmado.
Foto: Pascal Rossignol - Reuters